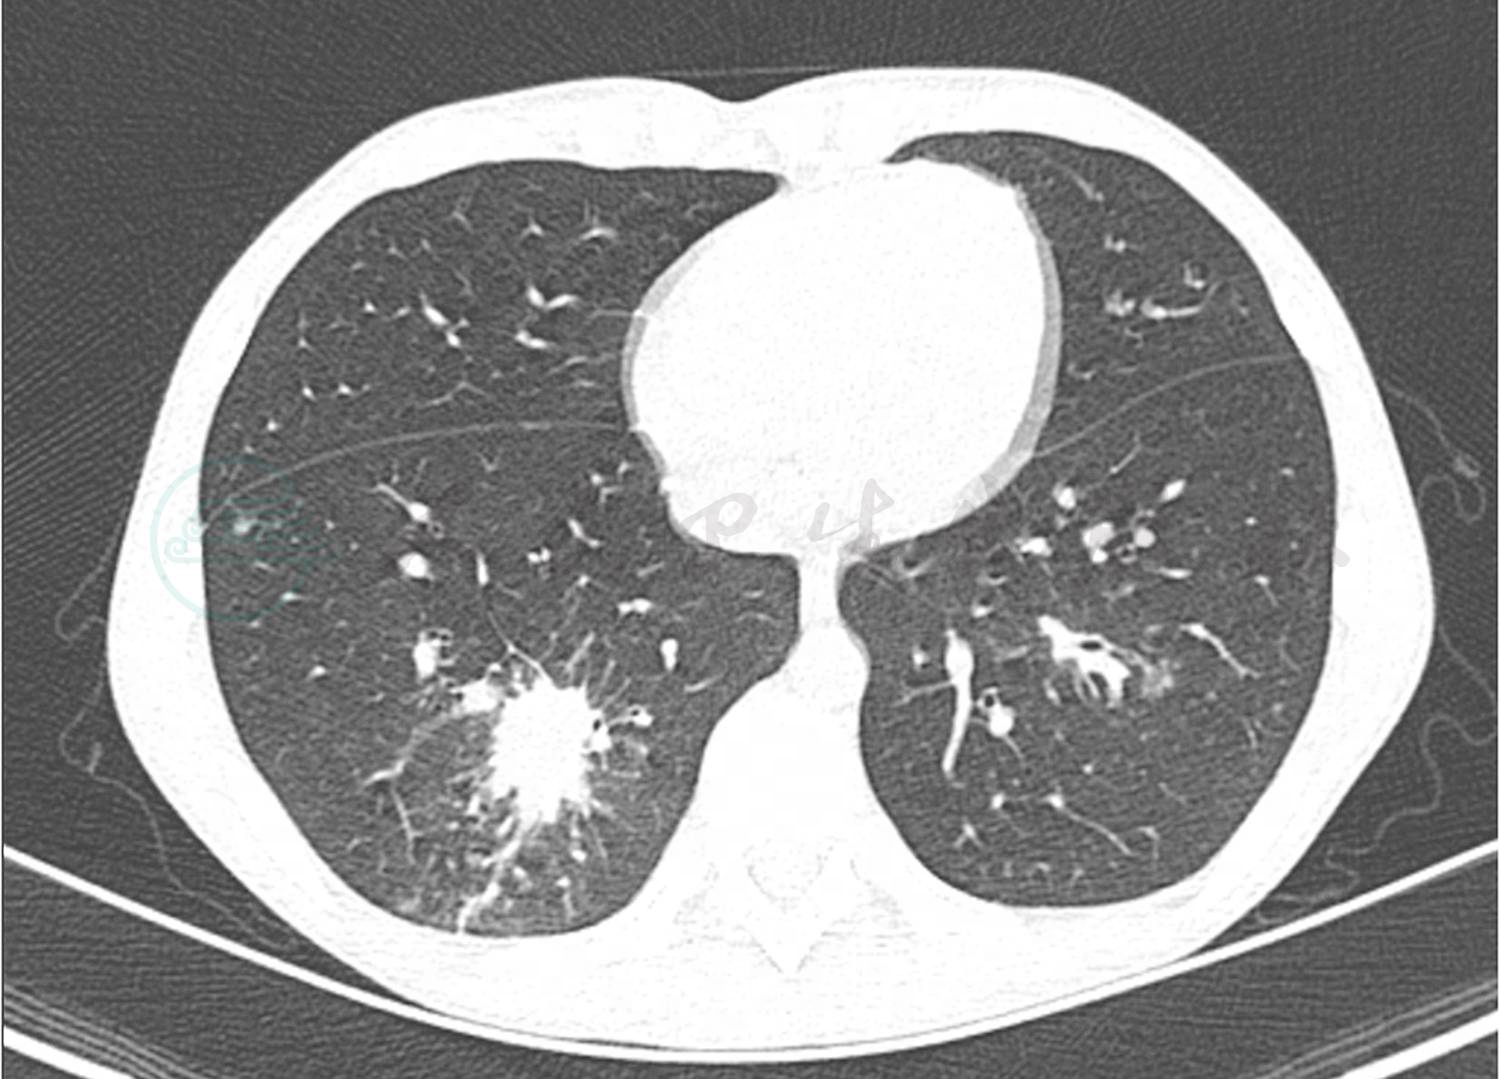
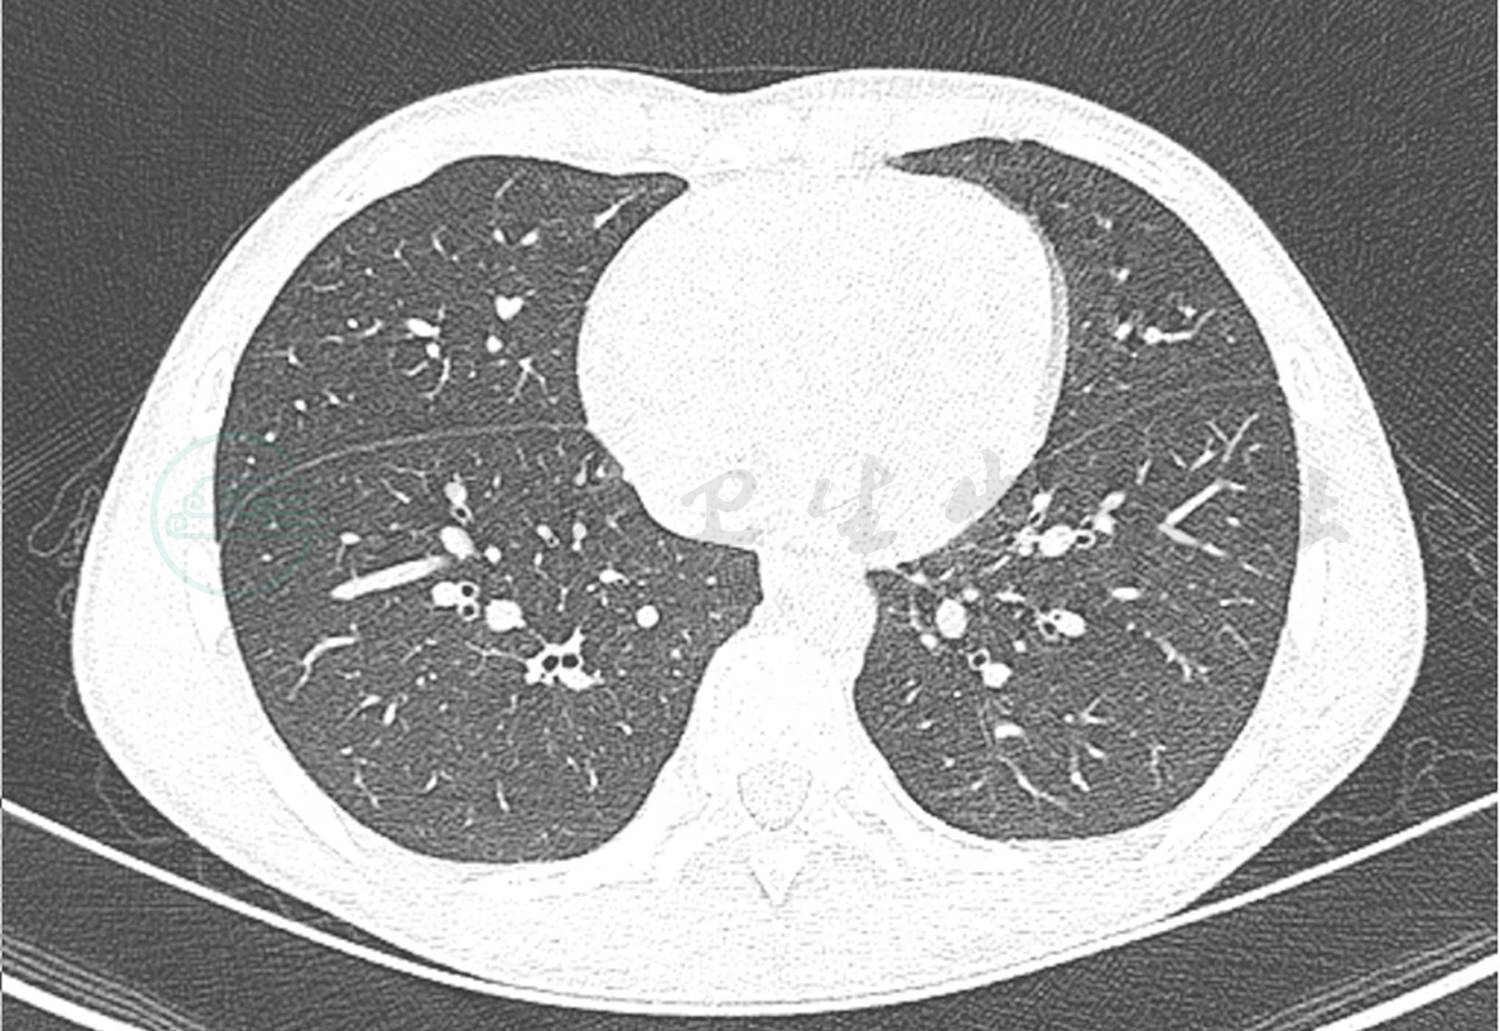
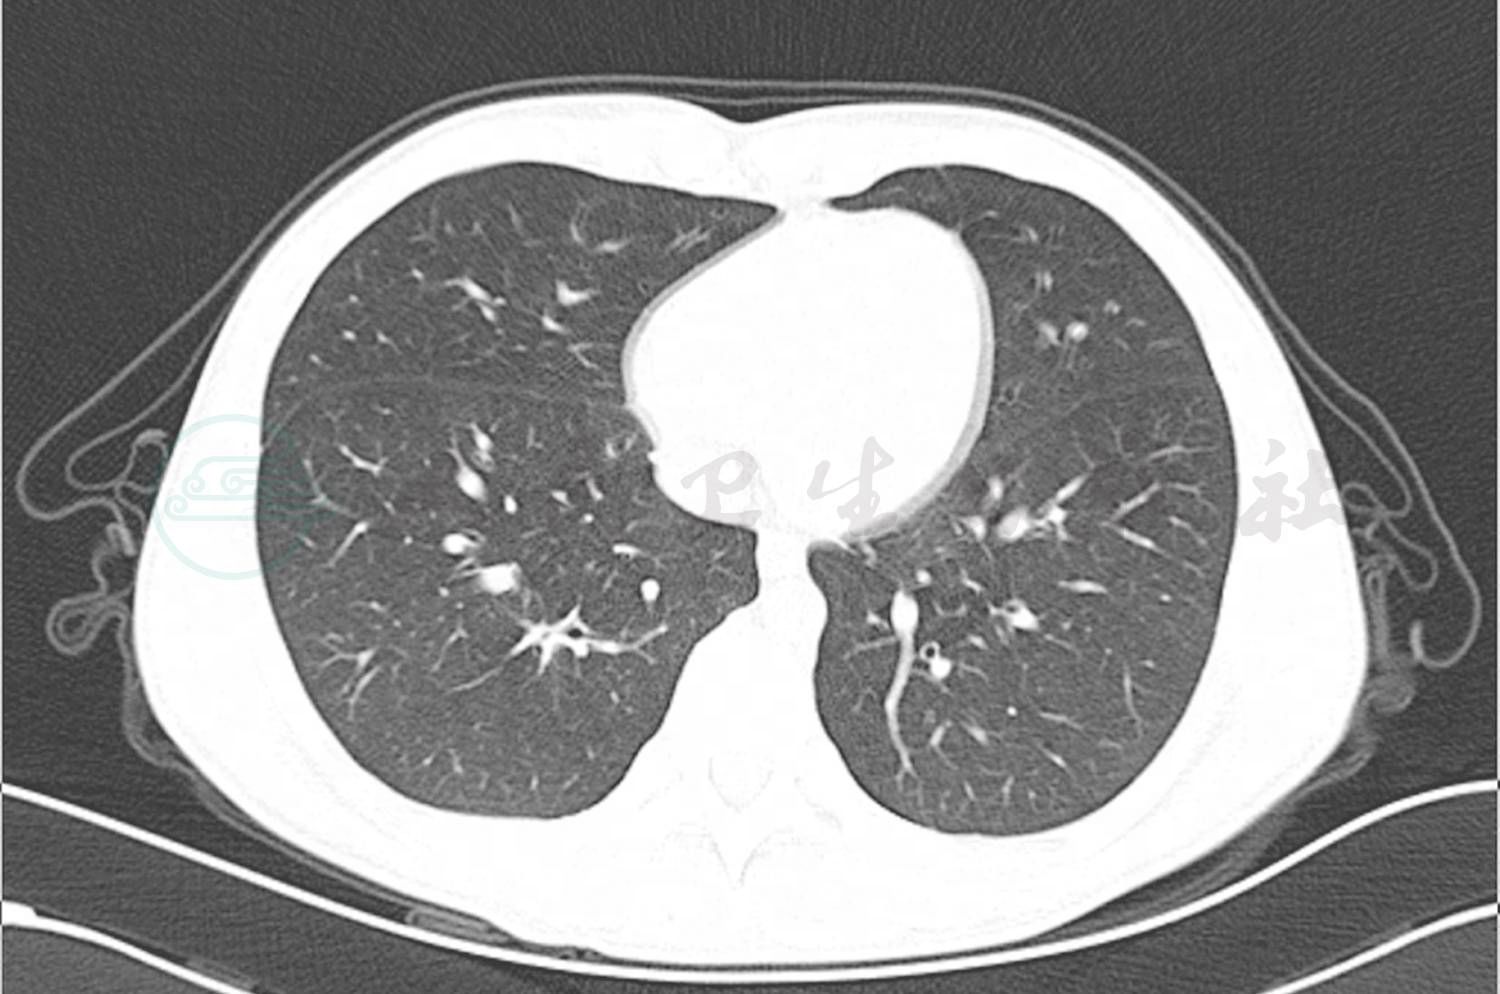

患儿,男,12岁。
主诉:反复多饮多尿1年余,呕吐伴昏迷4天,发热、咳嗽4天。
现病史:患儿1年前因“多饮多尿”于内分泌科诊断为1型糖尿病后院外间断未按规则应用胰岛素皮下注射治疗(具体不详),血糖控制不佳。1个月前患儿出现多饮多尿加重,日间饮水量约2000ml,日小便4~5次,每次尿量约500ml,夜尿增加,但量不详。7天前恶心、呕吐,为胃内容物,非喷射性,伴有腹痛,随之出现烦躁,意识不清,于当地医院住院治疗。血糖23.0mmol/L。血气分析:pH 6.99,考虑“酮症酸中毒”,给扩容补液胰岛素治疗。5天前患儿出现持续高热,体温波动在39.0℃左右,昏迷,球结膜水肿,咳嗽伴呼吸困难,少尿,转诊于笔者医院,收入PICU治疗,予气管插管呼吸机辅助通气,插管内可见新鲜血涌出,肺CT提示右肺下叶球形实变影,考虑肺部感染,给予头孢噻肟舒巴坦钠抗感染,胰岛素持续静脉滴注4天后患儿清醒,自主呼吸良好,监测血气正常,撤机,血糖波动在12mol/L左右,改为皮下胰岛素注射。但患儿仍有发热,发热间隔8~12小时,阵发性咳嗽,可咳出少许白痰伴血丝,复查肺CT提示右肺下叶球形实变影面积增大,为求进一步诊治,转入笔者科室继续治疗。
既往史:1年前诊断为“1型糖尿病”。
过敏及接触史:无食物及药物过敏史。无肝炎、结核等传染病接触史。
个人及家族史:否认糖尿病家族史。
入院查体及相关检查:体温38.7℃;脉搏120次/min;呼吸25次/min;血压110/50mmHg。神志清醒,一般状态及反应可,周身皮肤无皮疹及出血点,双肺呼吸音粗,可闻及密集中小水泡音,心音有力、律齐,各瓣膜区未闻及病理性杂音,腹部平软,四肢末梢温,CRT<3秒。神经系统查体未见异常。
辅助检查:血常规:白细胞计数10.3×109/L,中性粒细胞百分比84.2%,淋巴细胞百分比8.3%,红细胞计数4.36×1012/L,血红蛋白126g/L,血小板 150×1012/L;CRP 87.2mg/L;降钙素原7.22ng/ml;DIC基本正常;肝功能正常;痰培养未见细菌真菌生长;血培养未见细菌生长;6天前肺CT显示双肺多发渗出,以右肺下叶为主伴有实变,双侧胸腔积液(图1);入院前1天肺CT显示双肺下叶实变范围较前增大。双侧胸腔、右侧叶间积液较前减少(图2)。

图1 入院前6天肺CT

图2 入院前1天肺CT
转入笔者科室立即完善相关病原学检查提示GM试验阴性,1,3-β-D葡聚糖 <10µg/L,痰培养及血培养均阴性,PPD 阴性,结核斑点试验(T-spot)阴性,以上检查均未找到明确病原体。入院第5天完善纤维支气管镜检查,镜下示(图3)右肺下叶B10亚段可见大量黄白色类干酪样物质阻塞及坏死黏膜附着管壁,予毛刷刷检,刷检时黏膜有出血,予万分之一盐酸肾上腺素冲洗止血,将刷检物质送病理检查。根据镜下改变,高度怀疑支气管内膜结核及真菌感染。经胸科医院会诊,建议诊断性抗结核治疗,但家属拒绝。给予患儿伏立康唑抗真菌治疗,7天后体温恢复平稳,无咯血,复查肺CT(图4)提示右肺下叶后底段支气管旁高密度团块影较前减小。入院第12天病理结果回报(图5)提示炎性渗出坏死物及霉菌。

图3 入院第5天支气管镜下改变

图4 支气管镜后7天复查肺CT

图5 支气管镜下病理结果
予患儿出院,院外继续口服伏立康唑及规则进行皮下胰岛素治疗。2周后于门诊复查肺CT(图6),原病变较前好转,但右肺下叶靠近肋膈胸膜旁出现新斑片影,继续抗感染治疗。2个月后患儿无发热,无明显咳喘,无咯血,复查肺CT双侧肺部病变明显吸收(图7),继续口服抗真菌药物治疗。5个月后再次于门诊复查肺CT基本吸收,提示右肺下叶后端支气管闭塞,复查支气管镜(图8)提示右肺下叶B10亚段开口狭窄;考虑患儿肺CT仍有少许片影,嘱继续口服伏立康唑巩固治疗1个月后停药,总疗程6个月。出院7个月后复查肺CT(图9),双肺仅留下模糊条索影,1年后(停药6个月)复查肺CT(图10),无进展,提示治愈。
图6 出院2周后复查肺CT结果

图7 出院2个月后复查肺CT结果

图8 出院5个月后复查支气管镜
图9 出院7个月后复查肺CT
图10 出院1年后复查肺CT
儿童糖尿病合并肺部侵袭性真菌感染。
诊断依据:1型糖尿病患儿,未按规则使用胰岛素,血糖控制不佳,高血糖为真菌尤其是毛霉菌良好的培养基,肺CT提示双肺渗出性改变,右肺下叶球形实变影。支气管镜活检病理结果回报提示炎性渗出坏死物及霉菌。抗真菌治疗有效。
真菌是自然界中微生物的一个大类,是数量庞大的真核细胞类生物,主要以寄生或腐生方式生存。人类生存的环境中,侵入人体可导致真菌性疾病的真菌约有300种,这些致病菌多为条件致病性真菌。因肺循环具有低压力、低阻力及高容量的特点,且肺脏与外界环境沟通,决定了肺脏是真菌感染最常受累及的部位。毛霉菌病又称接合菌病、藻菌病,是毛霉目真菌引起的一类条件致病性真菌病,也是最严重的侵袭性真菌感染之一,在正常人群中很少致病,近年来发病率呈上升趋势。毛霉菌病的特征性病理改变为浸润、血栓形成和坏死,具有极强的侵袭性。因此,毛霉菌通过以下几种机制作用于宿主,最终导致肺部病变:①真菌侵入支气管-肺组织后,机体自身免疫力与真菌抗衡失败后,在支气管-肺组织生长繁殖的真菌阻塞支气管,破坏宿主组织细胞;②真菌侵入宿主后产生内毒素、酶类等物质,宿主若免疫力下降不能抵抗真菌释放的物质,导致机体组织细胞被真菌释放的毒素等物质破坏;③菌丝易穿透管壁,侵袭血管壁和血管腔,形成肺动脉栓塞、出血性肺梗死和假性动脉瘤等,这也是造成临床上咯血比例高的主要因素。
与糖尿病相关的毛霉菌病多见于血糖控制不佳的患者,其死亡率为32%~57%。糖尿病尤其是DKA患者易发生毛霉菌感染的原因是:①糖尿病患者免疫功能发生改变,表现为多形核白细胞趋化性降低,血管内皮细胞迁移受损及产生的超氧化物减少;②发生DKA时能破坏血清转铁蛋白结合铁的能力,释放的游离铁增加了真菌繁殖力;③真菌体内的酮还原酶还可使毛霉菌在新陈代谢过程中利用宿主体内的酮体,从而增加宿主对真菌的易感性;④高血糖和血清pH低下减弱了中性粒细胞对菌丝的趋化性和黏附性,也减弱了肺泡巨噬细胞对芽胞和菌丝的抑制作用。
肺毛霉菌的影像学改变不特异,与肺结核及其他的侵袭性肺部真菌感染尤其是肺曲霉病很难鉴别。现有人总结毛霉菌胸部CT表现:双肺多发肺结节(>10个),可伴有胸腔积液,进展迅速的边缘模糊斑片状实变影常伴空洞形成,此病空洞有一定特点:多发,多为厚壁(至少2mm)。空洞外壁可不规整,多数无明显短毛刺,部分可见多发长毛刺,但短毛刺极少见;多数空洞内壁是光滑的;反晕轮征(和晕轮征的表现相反,在胸部高分辨率CT肺窗上观察,病灶中心密度低,呈磨玻璃状,周围是新月形或环形高密度);增强扫描显示病灶内部易出现坏死液化,出现不均匀强化或欠规则环形强化,实性部分通常强化明显,CT值最多增加了32HU,且以延迟强化为主。肺曲霉菌病:多为薄壁空洞,伴有“洞中球征”者。结核空洞:一般好发于上肺尖后段,或下叶背段,多为薄壁空洞,进展相对缓慢,常伴有卫星灶;而肺毛霉菌病空洞无好发位置,多为厚壁,进展快,易有肺动脉栓塞形成。总之,肺毛霉菌病胸部影像表现多数征象特异性不强,若影像表现为多发厚壁空洞,且进展较快,又合并肺动脉栓塞时应考虑到本病的可能。
目前临床上鉴定真菌采用的方法有多种,在实际应用中各有利弊。真菌培养历时长且易出现假阴性;近年来开展的分子生物学诊断技术,如针对真菌抗原检测的G试验、GM试验,在毛霉菌感染时为阴性。组织学病理诊断是金标准,在显微镜下进行形态学观察方便快捷,但有时与其他菌种很难鉴别。毛霉菌的形态学特点为:菌丝粗(直径5~15μm),分枝不规则,很少分隔。这与曲霉菌的菌丝刚好相反,较具特征性;有时毛霉菌和曲霉菌在镜下很难区别,可运用以下三步法作出鉴别诊断:①采用荧光染色法观察菌丝是否有隔膜:钙荧光白是一种荧光增白剂,能与真菌细胞壁的纤维及几丁质发生特异性结合,使真菌在荧光显微镜下发出浅蓝色荧光,易于辨认,一般认为若观察到菌丝无隔膜为毛霉菌,有隔膜则为曲霉菌。②GM试验:检测的是半乳甘露聚糖,这是曲霉菌特有的细胞壁多糖成分,若GM试验阳性,在很大程度上提示了曲霉菌感染;若阴性,继续进行第三步。③针对毛霉菌DNA进行PCR检测。
肺毛霉菌病治疗成功的关键在于去除危险因素、清除坏死组织和早期应用抗真菌药。去除危险因素是治疗成功的基础,合并肺毛霉菌病的糖尿病酮症酸中毒患者,应尽快将血糖控制在正常范围内,快速补液达到酸碱平衡。由于毛霉菌具有血管阻塞、组织坏死的特性,药物很难到达病变组织,因此局限性病变能耐受手术者均应考虑外科手术治疗,术后继续抗真菌。药物治疗首选两性霉素B脂质体,是最广谱的抗真菌药物,对隐球菌、念珠菌和曲菌的代谢有特异性的抑制作用,具有很强的杀菌能力,但该药对肾毒性大,易引起肾衰竭,对已有肾功能损害的患者要慎用。伏立康唑在主要器官、组织、体液中具有较好渗透能力,副作用小,可用于儿童用药及肾功能损害者。尽早应用是治疗成功的关键,通常情况下,需要1周达到稳态血药浓度。此外,有少数文献报道高压氧疗、细胞因子治疗如IFN-γ和GM-CSF可在一定程度上提高吞噬细胞的吞噬能力,故可作为肺毛霉菌病的辅助治疗,但确切疗效还将得到进一步的临床证实。
糖尿病合并真菌感染的预防应注重餐前、尤其餐后血糖的测定,积极控制血糖,增强糖尿病患者的免疫力,重视血糖监控。综上所述,当糖尿病DKA患者出现肺出血,肺部影像学提示多发厚壁空洞,胸腔积液,高度怀疑肺毛霉菌病,应及早进行支气管镜活检查找病原体,进行早期诊断及治疗,减少死亡率。
(程 琪 尚云晓)













